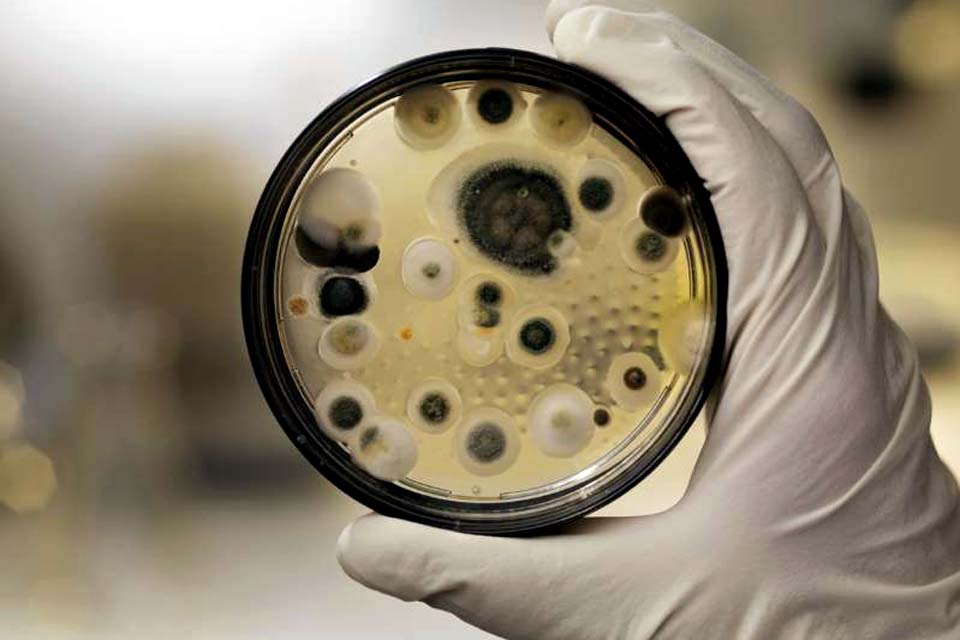
Superfungo encontrado no Brasil mata 39% dos contaminados

Por Catraca Livre
Publicada em 10/12/2020 às 09h55
O superfungo Candida auris que acendeu o alerta vermelho da Anvisa (Agência Nacional de Vigilância Sanitária) tem uma taxa de mortalidade alta. Segundo um estudo publicado na BMC Infectious Diseases, 39% dos contaminados acabam perdendo a vida.
Ainda de acordo com o artigo, há ao menos 4,7 mil casos de infecção pela Candida auris já registrados em 33 países, como Espanha, Venezuela, Índia, Paquistão e Estados Unidos.
Por ser um fungo letal e que se espalha facilmente, principalmente em ambientes hospitalares, o surgimento de novos casos preocupa autoridades em todo o mundo.
No Brasil, o microrganismo foi identificado na última sexta-feira, 4, no cateter de um paciente internado com covid-19 na UTI de um hospital privado de Salvador, na Bahia.
Foram realizadas duas contraprovas, sendo uma no Laboratório Central de Saúde Pública da Bahia (Lacen-BA) e outra na Universidade de São Paulo, que é a referência nacional do Ministério da Saúde, testando positivo em todas as ocasiões.
Desde 2017, laboratórios brasileiros de referência analisam amostras suspeitas que são encaminhadas pelos estados, mas nunca antes houve o registro de nenhum caso de infecção por C. auris.
Alerta e prevenção
A Anvisa chegou a emitir um alerta na última terça-feira, 8, afirmando que o Candida auris é um fungo que representa grave à saúde global e que algumas cepas dele são resistentes a todas as principais classes de fármacos antifúngicos.
Junto com o alerta, a Agência publicou o Comunicado de Risco, contendo orientações para a vigilância laboratorial, encaminhamento de isolados para laboratórios de referência e medidas de prevenção e controle de infecções pela C. auris.
A força-tarefa nacional foi organizada para acompanhar o caso e prevenir a disseminação do microrganismo no país. As autoridades de saúde também investigam se o caso de Salvador é isolado ou se o fungo já se espalhou.
 imprimir
imprimir














